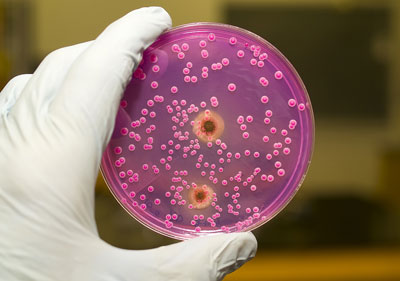
gribok-Candida Посев на грибок кандида

Что такое кандидоз — это воспаление, вызванное грибками рода Candida. Эти грибки в норме могут жить на коже и слизистых человека, но при ослабленном местном иммунитете вызывают их воспаление. Кандидозу в той или иной степени подвержены все участки кожи и слизистых оболочек. Встречается кандидоз полости рта (кандидозный стоматит), ушей (отомикоз), ногтей (онихомикоз), раневых поверхностей, половых органов. Другое название кандидоза слизистых оболочек — молочница, оно связано с тем, что один из признаков заболевания проявляется как белые выделения, напоминающие по внешнему виду творог или кислое молоко.
Причины и провоцирующие факторы
В минимальных количествах грибки находятся на коже большинства людей, но нормальная микрофлора и иммунная система обычно сдерживают их размножение.
Поэтому основные причины кандидоза — это:
- лечение антибиотиками,
- патологии иммунной системы, в том числе ВИЧ и врожденные патологии,
- хронические заболевания,
- сильная травма кожи и слизистых.
Дополнительными провоцирующими факторами могут стать высокая влажность в пораженной области (в складках кожи у людей с избыточным весом и у детей, в ушах у пловцов, в половых органах, особенно при несоблюдении личной гигиены, в полости рта), различные заболевания, «отвлекающие» на себя иммунную систему. Немалую роль в развитии кандидоза играет психосоматика: люди, чаще подверженные стрессу, больше страдают кандидозом. Это связано с изменением гормонального фона при стрессе и влиянием этих изменений на иммунную систему.
Кандидоз может быть профессиональным заболеванием: например, часто отмечается онихомикоз у продавцов овощей и фруктов.
Врачи отмечают, что кандидоз, вызванный грибами рода Candida, является распространенной инфекцией, которая может поражать различные участки тела, включая кожу, слизистые оболочки и внутренние органы. Особенно часто кандидоз наблюдается у людей с ослабленным иммунитетом, диабетом или принимающих антибиотики. Симптомы могут варьироваться от зуда и жжения до более серьезных проявлений, таких как воспаление и выделения. Специалисты подчеркивают важность своевременной диагностики и лечения, так как запущенные случаи могут привести к серьезным осложнениям. Профилактика включает поддержание гигиены, правильное питание и укрепление иммунной системы. Врачи рекомендуют обращаться за медицинской помощью при первых признаках инфекции, чтобы избежать дальнейших проблем со здоровьем.

Кандидоз женских половых органов
Молочница половых органов у женщин считается наиболее частой половой инфекцией. У женщины на состояние микрофлоры и иммунной системы оказывают влияние, кроме всего прочего, гормональные циклы, поэтому наиболее часто встречается молочница после родов и во время месячных. Конечно, заболевание бывает и при беременности на любом сроке, но не так часто, как в других случаях.
Кстати, молочница после овуляции случается довольно редко. Ее развитию способствует несоблюдение личной гигиены, ношение тесной и неудобной одежды, перегрев области половых органов, малоподвижный образ жизни, избыточный вес, постоянное нервное переутомление. В случае, если одной из причин является психосоматика, может развиться рецидивирующий кандидоз, который очень трудно вылечить.
Симптомы молочницы половых органов:
- Выделения из влагалища, белые или беловато-желтые, имеющие вид комочков творога или прокисшего молока. Часто имеют запах рыбы.
- Зуд и жжение, иногда боль в области влагалища, постоянные, увеличиваются при неудобном положении тела, усилении потоотделения.
- Болезненность во время полового акта, иногда — во время мочеиспускания и дефекации.
- Покраснение кожи половых губ.
Выраженность этих симптомов может варьироваться от незначительных до интенсивных. Женщины часто стесняются обратиться с молочницей к гинекологу и задаются вопросом, может ли молочница пройти сама собой. Иногда бывают случаи самоизлечения, но гораздо чаще без лечения есть риск хронизации инфекции.
Несмотря на то, что молочница — это инфекционное заболевание, инфицирования как такового при ней не происходит, ведь грибок живет практически у всех здоровых взрослых людей, по той же причине отсутствует и ярко выраженный инкубационный период молочницы.
Осложнения патологии
Опасна ли молочница для женского организма? Она может стать источником самозаражения и кандидоза других органов. При тяжелых патологиях иммунной системы есть риск развития генерализованного кандидоза и кандидозного сепсиса. Во время беременности вагинальный кандидоз может быть причиной преждевременных родов, инфицирование околоплодных вод, плаценты и плода.
Многих женщин интересует, можно ли заниматься сексом во время молочницы. Риск заражения партнера при этом довольно мал, но полностью не исключен. Кроме того, во время полового акта возникают неприятные ощущения, иногда он резко болезненный, так что удовольствие от секса выходит весьма сомнительным.
Иногда бактериальные заболевания половых органов могут протекать с симптомами, похожими на молочницу. Это очень опасная ситуация, ведь препараты от молочницы в таком случае неэффективны, а настоящая болезнь остается без лечения. Симптомы заболевания, похожего на молочницу, являются опасными, если:
- признаки патологии сохраняются после курса лечения,
- во время курса лечения остаются или усиливаются признаки молочницы,
- признаки молочницы появляются меньше чем через два месяца после завершения курса лечения,
- во время курса лечения раздражение половых органов усиливается,
- на фоне молочницы появилась высокая температура, общая слабость,
- появились кровянистые или гнойные выделения на фоне лечения.
При наличии этих симптомов нужно немедленно обратиться к врачу, самолечение в этом случае не будет эффективным.
Кандидоз — это грибковая инфекция, вызванная избыточным размножением грибов рода Candida, чаще всего Candida albicans. Многие люди сталкиваются с этой проблемой, но не всегда понимают ее природу. Симптомы могут варьироваться от зуда и жжения до выделений и покраснений, что делает кандидоз неприятным и порой болезненным состоянием. Часто его связывают с ослаблением иммунной системы, антибиотикотерапией или гормональными изменениями. Люди делятся опытом о том, как важно поддерживать баланс микрофлоры, правильно питаться и соблюдать гигиену. Некоторые отмечают, что стресс и недостаток сна также могут способствовать развитию инфекции. Важно помнить, что при первых признаках кандидоза стоит обратиться к врачу для получения квалифицированной помощи и назначения адекватного лечения.

Диагностика
Определить наличие у себя молочницы в домашних условиях не всегда возможно. Многие заболевания могут сопровождаться выделениями и при этом иметь бактериальную природу, а значит, средства, эффективные против молочницы, будут бесполезны. Гинеколог, чтобы вынести определение молочницы, назначит следующие диагностические процедуры:
- Общий гинекологический осмотр в зеркалах. Позволяет увидеть внешние признаки молочницы, а также оценить состояние наружных половых органов, стенок влагалища и шейки матки.
- Мазок из влагалища. Вагинальное отделяемое проходит бактериологическое и микологическое исследование, позволяющее выявить возбудителя инфекции.
Противогрибковое лечение назначается только в том случае, если подтвержден диагноз кандидоза и грибки найдены в отделяемом.
Лечение
Основной препарат для лечения молочницы — Флуконазол (Дифлюкан).
Кроме него существуют также другие препараты: Кетоконазол, Миконазол, Тиоканазол и др. Их применяют в виде гелей, кремов и мазей, которые наносят на область половых органов, вагинальных таблеток и свечей, таблеток для приема внутрь при сильно выраженных симптомах. Перед нанесением крема или геля нужно тщательно вымыть пораженную область. Курс лечения длится до 14 дней. Назначаются успокоительные препараты, чтобы снизилась психосоматика, точнее, ее влияние, а после курса лечения — пробиотики, чтобы произошло восстановление микрофлоры после молочницы. При тяжелых запущенных случаях кандидоза необходима госпитализация.
Лечение рекуррентной (возвратной) молочницы у взрослых проводится по специальным схемам: начальной и поддерживающей. В начальную фазу назначают вагинальные свечи Клотримазол, мазь Флуконазол или таблетки Итраконазола, в поддерживающей фазе те же препараты применяются в меньших дозах раз в несколько дней.
Вопреки расхожему мнению, применение спринцеваний различными веществами не лечит молочницу, но при этом нарушает кислотно-щелочной баланс и состояние микрофлоры влагалища, тем самым способствуя ухудшению состояния и хронизации процесса. Эффект от лечения народными средствами обычно связан с тем, что болезнь может быстро самоизлечиться.
Молочница половых органов у мужчин
Причины возникновения молочницы у мужчин те же, что и у женщин, — нарушение состояния микрофлоры и иммунной системы, несоблюдение личной гигиены, ношение неудобной одежды, провоцирующей избыточное потоотделение, психосоматика.
Симптомы молочницы у мужчин — творожистый налет в области головки полового члена, зуд и жжение в половом члене, покраснение кожи полового члена и мошонки, болезненность во время полового акта. Риск передачи заболевания половым путем довольно мал, но наличие молочницы у одного из половых партнеров может спровоцировать ее развитие у другого партнера.
Кандидоз у мужчин диагностируют по данным осмотра половых органов и результатов мазка из мочеиспускательного канала. Диагноз ставится в том случае, если выявлен возбудитель в мазке.
Для лечения применяются в основном кремы, содержащие противогрибковые препараты, реже — таблетки. При нанесении крема нужно тщательно вымыть пораженный участок и полностью оголить головку полового члена. Курс лечения у взрослых мужчин длится до 5 дней. В случае рекуррентной молочницы, которая у мужчин встречается довольно редко, применяется та же схема, что и у женщин.
Кандидоз половых органов бывает не только у взрослых, но и у детей. Он случается довольно редко, но при этом имеет тенденцию к быстрому распространению с кожи половых органов на мочеиспускательный канал, область между ягодиц, прилежащие складки кожи. Причиной молочницы могут быть нарушения в иммунной системе, неправильный уход за кожей ребенка, несвоевременное лечение потницы. Группа заболеваний кожи у детей грудного возраста, вызванная различными причинами, объединяется под общим названием пеленочного дерматита.
Для лечения молочницы у детей применяются те же препараты, что и у взрослых, только в меньших дозах. Схема их применения зависит от возраста ребенка. Рекуррентная молочница у детей обычно не развивается.
Профилактика молочницы
Профилактические меры включают следующее:
- если назначен прием антибиотиков, после курса употреблять пробиотики, восстанавливающие нормальную микрофлору,
- при наличии хронических заболеваний — соблюдение рекомендаций врача,
- при болезнях иммунной системы — прием иммуномодуляторов по назначению врача,
- соблюдение личной гигиены,
- ношение удобной одежды и белья, недопущение перегрева и избыточного потоотделения.
Молочница является одним из самых частых заболеваний половых органов, в некоторых случаях она имеет склонность к самоизлечению. Но иногда она становится причиной различных осложнений, поэтому ее лечение лучше начинать как можно раньше. К тому же многие более опасные заболевания могут маскироваться под молочницу, поэтому неэффективность курса лечения от патологии должна насторожить и стать поводом для немедленного визита к врачу.
https://youtube.com/watch?v=vFDEr_GgHZE%3Ffeature%3Doembed
Вопрос-ответ
Как понять, что у тебя кандидоз?
В этом случае симптомы кандидоза – налет на половых органах в виде пленки. Также характерны покраснение слизистых и кожи, дискомфорт, зуд, жжение при мочеиспускании. Кандидоз ротовой полости (оральный кандидоз, кандидоз полости рта) представляет собой еще одну распространенную разновидность заболевания.
Откуда берется грибок кандида?
Причиной заболевания являются дрожжеподобные грибы, которые обитают в организме каждого человека. Спровоцировать интенсивное размножение грибка может множество факторов. Например, переохлаждение, болезнь, стресс, изменение гормонального фона (во время беременности или приеме гормональных препаратов).
Как убрать кандидоз из организма?
Кандидоз лечится противогрибковыми препаратами и в среднем проходит за 2 недели. При подозрении на симптомы кандидоза полости рта можно обратиться к терапевту, стоматологу или гастроэнтерологу, мочеполовой системы — к гинекологу или урологу, а в остальных случаях — к терапевту.
Чем опасен кандидоз?
Нарушение кишечной микрофлоры – частый синдром, который может приводить к нарушениям иммунитета и влиять на качество жизни человека. Кандидоз кишечника – состояние активного размножения в ЖКТ грибков. Без лечения патология приведет к попаданию инфекции в кровоток и поражению других органов.
Советы
СОВЕТ №1
Регулярно проходите медицинские обследования, особенно если у вас есть предрасположенность к грибковым инфекциям. Это поможет выявить кандидоз на ранней стадии и начать лечение вовремя.
СОВЕТ №2
Поддерживайте иммунную систему, правильно питаясь и ведя активный образ жизни. Употребление продуктов, богатых витаминами и минералами, может помочь предотвратить развитие кандидоза.
СОВЕТ №3
Избегайте избыточного использования антибиотиков, так как они могут нарушить баланс микрофлоры и способствовать развитию грибковых инфекций. Обсуждайте с врачом необходимость их применения.
СОВЕТ №4
Следите за личной гигиеной, особенно в теплую и влажную погоду. Носите свободную одежду из натуральных тканей, чтобы снизить риск размножения грибков.